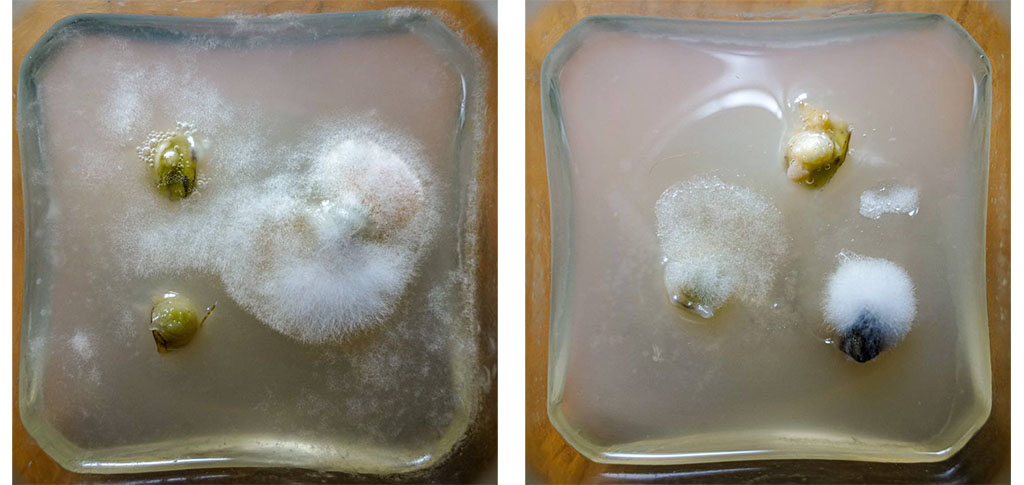

С детства люблю растения. Не скажу, что между нами было что-то серьезное, но связь поддерживалась всю жизнь. Вместо растений я с головой ушел в IT, программирование и ML. И так бы жил, пока однажды мне не попалась статья, пробросившая мостик от моих навыков к давней любви. Это запустило цепочку событий (посмотрите у меня в профиле последние посты), которая длится уже 3 года и привела к идее строительства фермы по выращиванию настоящего васаби в Подмосковье.

Настоящий васаби

Мало кто пробовал настоящий васаби, тем более свежий. То, что мы привыкли видеть рядом с роллами — не васаби. Эту субстанцию готовят из порошка горчицы или хрена, подкрашивают в зеленый и получается «васаби». В редких случаях добавляют небольшую долю порошка настоящего васаби. Но даже порошкообразный настоящий васаби — это совсем не то. Например, если вы пробовали имбирь в порошке, то поймете о чем я. Острота есть, вроде и на вкус похоже, но свежий сильно отличается. Свежий васаби содержит больше эфирных масел и других летучих соединений, чем в порошке.
Культивирование васаби в Японии
Любопытно, что в дикой природе ареал произрастания васаби выпадает лишь на 3 страны: Японию, Корею и Россию. Так что васаби — вполне себе русское растение. Но, справедливости ради отмечу, что только в Японии наилучшим образом сошлись два основных фактора для культивирования: природные условия и население, находящееся поблизости.
Есть два подхода к выращиванию васаби: на грядках или в природной гидропонике. Продукция от первого подхода считается ниже качеством, стоит дешевле и чаще отправляется на переработку. Кстати, у васаби съедобно всё: корневище, листья и цветы. Корневище, выращенное на природной гидропонике ценится выше за вкусовые качества и обычно идет в рестораны и на прилавки магазинов. Стоимость 1 кг составляет около $250. Цена впечатляет, но обоснована реальными трудностями, связанными с выращиванием.
Гидропонные плантации размещают на склонах в местах присутствия чистых горных рек или родников. Сажают растения в гальку и пускают по ним горную воду. Температура воды в течение года должна быть стабильной — 10°C - 17°C. Вода должна быть чистой и максимально насыщенной кислородом. Васаби не переносит прямых солнечных лучей длительное время, и не любит температуру окружающей среды выше 26°C. Для выращивания требуется высокая влажность. А ещё васаби растет очень медленно: от момента посадки до сбора проходит 18-24 месяцев. А это значит, что растение должно пережить зиму, а то и две.

Цена на васаби растет из года в год, т.к. поднимается мировой спрос, а место для естественной культивации ограничено. Кроме того в Японии падает урожайность. Люди жалуются на потепление климата, а из-за повышенной температуры образуется гниль и плесень. Жалуются на качество воды в горных реках. Японские кедры и кипарисы, которые активно высаживали в горах после Второй мировой теперь портят сложившуюся экосистему. Жалуются на диких животных, которые стали забираться выше в горы и поедать васаби. Жалуются, что число горных потоков сокращается, а вместе с тем и число ферм. В Японии ограниченное число мест для комфортного выращивания культуры и все они заняты. Наряду со снижением производства васаби в Японии, и ростом глобального интереса, фермы начинают появляться по всему миру.
А есть ли смысл выращивать в РФ?
Я считаю, что есть. Во-первых, рестораны в России, особенно в Москве и Питере одни из лучших в мире, а суши и роллы у нас делают на каждом шагу. Настоящий васаби — отличный способ выделиться среди конкурентов. Каждый уважающий себя премиальный ресторан с японской кухней просто обязан подавать настоящий васаби.
Во-вторых, население знает о существовании васаби и что это примерно такое. Но в то же время мало кто понимает, что пробовал только ненастоящий. С одной стороны это недостаток, т.к. рынка настоящего васаби практически не существует, с другой стороны преимущество, если пытаться этот рынок создавать, учитывая, что некоторая осведомленность у населения присутствует. У людей возникает неподдельное желание попробовать настоящий продукт, когда они узнают правду.
В-третьих, я уже знаю, что интерес к васаби есть. Я написал пару постов про васаби на Пикабу и мне периодически пишут желающие купить, жаль только, что продавать пока нечего.
В общем, ребята, я решил, что оно того стоит и буду вкладываться. Как минимум, будет весело. За дело!
Поиск посадочного материала
Я начал искать семена. Обгуглил всё, в России не продаются. Нашел лот на Алиэкспресс, где пишут, что «семена настоящего васаби» и прикладывают фото настоящего васаби. Заказал. Пришли семена редиски.

Нашел лот на европейском сайте, сделал заказ на адрес знакомого в Турции. От сайта ни ответа, ни привета, ничего не получил. Позже узнал, что практически весь рынок семян васаби, за исключением профессионального — фейковый. Настоящие семена не продают из-за короткого срока хранения и низкой всхожести.
Тогда мне пришла в голову гениальная идея попробовать укоренить корневище, которое продают для еды. В РФ нашелся единственный поставщик васаби из Японии, но на тот момент он не принимал заказы. Есть и другие страны, где продают васаби. Но прежде, чем отправиться за границу самому, решил попробовать заказать с доставкой.
Нашел интернет-магазин в Лондоне, сделал заказ в местный пункт СДЕКа, чтобы потом переправить домой. Курьер привез заказ в СДЕК, огонь! Вот только в РФ его отказались пересылать, т.к. товар относится к скоропортящимся продуктам. Пришлось ещё и за утилизацию заплатить.
Ещё я узнал, что васаби в РФ иногда привозят в виде саженцев продавцы редких растений. Нашел в сети двух, у кого когда-то в продаже были желанные растения, связался, в наличии нет и не ясно, когда будет.
А потом на связь вышел продавец пищевого васаби и сказал, что собирает заказ из Японии, и брать ли на меня. Конечно же я согласился. Так у меня появились свежие корневища, целый килограмм, осталось только превратить их в живые растения.

Сборка установки для укоренения
Я увлекаюсь аэропоникой, а аэропоника хорошо подходит для укоренения. К тому же в изначальном варианте я рассчитывал, что буду растить васаби именно на аэропонике. Поэтому буду собирать аэропонную установку. Сначала укореню в ней растения, а затем и выращу.
Охлаждение раствора. Элементы Пельтье
Известно, что васаби растет в холодной воде, поэтому буду собирать систему для охлаждения раствора. Самым простым решением показалось купить б.у. кулер для воды и использовать из него охлаждающий блок. Вынуть его оказалось легко, подключается он тоже просто — 12В на кулер и 12В на элемент Пельтье.
Блок состоит из элемента Пельтье, радиатора с вентилятором и камеры для воды с двумя выводами. Собрал тестовую систему, в которой через эти выводы циркулирует жидкость. В емкости было 15 литров. Чтобы видеть разницу температур, установил датчики снаружи и в воде.

По результатам видно, что за 30 часов температура жидкости стала на 8°C ниже окружающей среды. В целом, неплохо, но ещё не известно как это будет работать совместно с распылением из форсунок и дополнительной камерой под растения.

Аэропонная установка
Установка включает в себя бак, в котором охлаждается раствор при помощи элемента Пельтье. Бак обернут в термоизоляцию. Из бака раствор забирает насос от системы обратного осмоса, насос дает хорошее давление. Раствор пропускается через фильтр в 5 мкм и подается на форсунки, распыляющие его в емкости для выращивания. Из емкостей раствор возвращается обратно в бак для охлаждения.

Для поддержания уровня влажности воздуха поставил увлажнитель. Сделал освещение. Высадил корневища.

Установку обшил светоотражайкой.

Датчики температуры установил как снаружи, так в растворе и в зоне корней. Температура раствора получилась на 6-7 градусов ниже окружающей среды, но смысла в этом оказалось мало. Температура в корневой зоне почти не отличалась от температуры снаружи. Расход из форсунок низкий, распыление происходит не часто, поэтому раствор, который находится в системе между баком и форсунками успевает нагреться. Пришлось сделать доработку — поставить клапан перед форсунками, который сначала сбрасывал теплый раствор, а затем включалось распыление через форсунки уже с холодным раствором. Картина стала выглядеть следующим образом:

Теперь температура в корневой зоне (зеленая и оранжевая линии) где-то 2°C ниже температуры снаружи (синяя линия). Слабовато, но хоть что-то.
Неудача
На аэропонике корневища отказалить приживаться. Хоть некоторые и пустили корни, но и они начали гнить.

В то же время некоторые верхушки пытались расти, но в итоге все сгнило.

План B. Микроклональное размножение на минималках
Когда я посадил корневища на аэропонику, то придумал запасной план, решил попробовать применить цитокининовую пасту. Цитокинины — класс фитогормонов, стимулирующих деление клеток. Обычно используется для образования новых почек у растений, а так же входит в состав сред для микроклонирования. Удивительно, но паста сработала, у васаби появились новые почки.

Вероятно, если бы корневища протянули дольше, из этих почек можно было бы получить ростки. Тогда я впервые решил попробовать микроклональное размножение. Это вегетативный способ размножения, только берутся небольшие частички растения, которые помещаются в стерильные условия.

Я попытался сделать камеру с неподвижным воздухом, продезинфицировал как смог. Среда тоже немного отличалась от каноничной Мурасиге — Скуга. Нормальных фитогормонов в наличии не было, решил растворять цитокининову пасту, содержащую в составе 6-БАП (6-Бензиламинопурин), фитогормон, который должен подойти для ввода васаби в культуру in-vitro. Теоретически, всё могло бы сложиться успешно, но все кусочки с почками, которые я пытался ввести в стерильную культуру были с заражением, несмотря на попытку стерилизации, и благополучно испортились.
Попытка была довольно наивная, но надо же было с чего-то начать. Сейчас я значительно продвинулся в микроклональном размножении и ему будет посвящена вторая часть истории о моем пути к ферме васаби.
План C. Чик-чик и готово!
Мне попалось видео, на котором мужик взял маленькое корневище, почикал его на кусочки и поместил в горшок с субстратом. Я подумал, а вдруг у меня тоже сработает? Конечно, у него супер свежий образец, да ещё и остатки корневой имеются, и молодые они совсем, но всё же стоит проверить. Пришлось дозаказать ещё немного васаби. Посадил 20 кусочков корневища. И случилось чудо, 2 взошли! Один, правда, через некоторое время загнулся, но второй жив и по сей день.

И тут мне стало везти
Вышел на связь продавец редких растений и сказал, что будет делать заказ саженцев васаби из Голландии. Я попросил 5 штук. Через несколько недель приехали. Живые, настоящие, мои!

Гидропоника вместо аэропоники
Теперь у меня есть саженцы васаби аж из двух источников и надо их не продолбать. Ведь мало растения получить, надо ещё научиться их выращивать. Для начала хоть на каком-то уровне, чтобы в дальнейшем их размножить.
Аэропонная установка плохо себя показала при попытке укоренить корневища и я побоялся сажать в нее все 5 растений из европейского питомника. Посадил только одно, а для остальных четырех решил собирать гидропонную установку. С аэропоникой у меня до сих пор всё не так гладко как хотелось бы, а мне нужна уверенность, что растения выживут. Забегая вперед скажу, что решение это было верным. То растение, что я посадил в аэропонику не выжило.
Гидропонная установка
Выращивать решил в перлите. В качестве емкости для субстрата взял пластиковый ящик 400х300х230 и обшил пенофолом для уменьшения температурных потерь, т.к. планирую подавать в него охлажденный раствор.

Принцип действия установки прост. Раствор непрерывно нагнетается насосом в субстрат через трубки с капельницами. А из субстрата стекает обратно в растворный бак.
Система управления
Тут подробно останавливаться не буду, т.к. похожие вещи описывал в прошлых постах. Для управления установкой взял ESP32 и написал примитивную систему для работы устройствами. Включение/выключения реле для подачи питания на освещение, охлаждения раствора, работу насоса; сбор данных о температуре в различных точках, влажности воздуха; управление увлажнителем воздуха; логирование данных на сервер.

Охлаждение раствора в гидропонике
На этот раз никаких элементов Пельтье. Купил кулер с компрессором. Разобрал. Достал, не разрушая, охлаждающую систему, в ней компрессор остужает небольшой металлический бачок для воды. Я его обрезал и погрузил в свой растворный бак.

Работает значительно лучше, чем с элементом Пельтье.

На графике красная линия-пила — температура раствора. Пила потому, что компрессор работает не постоянно и автоматически отключается, когда температура раствора опускается ниже 12°C. Зеленая и оранжевая линии — температура в зоне корней. Синяя линия отражает температуру в зоне листьев.
Дружим увлажнитель воздуха с ESP32
Для васаби требуется повышенная влажность воздуха. Для этого я решил приспособить увлажнитель. Основная проблема с дешевыми увлажнителями воздуха, что при отключении электричества приходится заново включать их руками. А ещё хочется, чтобы увлажнитель реагировал на датчик влажности воздуха, который я установлю в нужном для себя месте. Поэтому попробую подружить его с ESP32.
Разобрал увлажнитель. Всё оказалось просто. Во-первых, в увлажнителе есть поплавковый выключатель, отключающий питание с испарителя, если закончилась вода. Подключаем его, минуя сенсорную кнопку, которая сбрасывается при отключении электричества. Во-вторых, есть управляющая плата с выводом PWM, который можно воткнуть в ESP32 и управлять интенсивностью работы УЗ-испарителя. В третьих разрываем цепь на УЗ-испаритель своим реле, которое реагирует на датчик влажности.

Посадка и выращивание
Я уже писал, что в гидропонику посадил 4 куста. По 2 в ящик 400х300х230. Обеспечил растениям комфортный климат, подобрал состав раствора для питания. Растения прижились и чувствуют себя отлично.

Цветение васаби и получение семян
Спустя некоторе время растения дружно зацвели.


А раз у меня есть цветущие растения, я попытаюсь получить семена. О том как опыляется васаби я не нашел никакой информации. У цветков, к которым не прикасался совсем стручки получились пустые, без семян. Тогда я пустил в ход кисточку, поработал пчелой, и это помогло. В некоторых стручках образовывалось по 1-2 горошине. В идеальных условиях должно получаться до 8, но и своему результату я был очень рад. В итоге собрал около 120 семян.

Семена васаби долго не хранятся, при высыхании погибают, поэтому я как можно скорее приступил к подготовке к посадке. В природе семенам васаби требуется стратификация (выдерживание на холоде) в несколько месяцев. Сократить период стратификации или вовсе его миновать помогает гиббереллиновая кислота (GA3) — гормон роста. Я нашел несколько статей, подтверждающих это для васаби. Сначала на 3 недели поместил семена в холодильник в нулевую зону, а затем на 8 часов замочил в GA3, 150 мг/л. Высаживал семена в торф с перлитом. Взошло 12 семян из 120. 10 из них живы по сей день, спустя 4 месяца после всходов.

Я есть Грут
Мысли о разможении васаби
Васаби выгодно размножать вегетативным способом. Каждый куст при сборе урожая даст 5-10 бесплатных крупных отростков, которые легко укореняются. Чтобы дорастить семечку до состояния такого отростка в среднем уйдет 4-5 месяцев. Так же не в пользу семян готовит низкая всхожесть, необходимость стратификации и зависимость от сезонности, когда растение дает семена.
А собирать васаби можно круглый год и сажать тоже, если климат позволяет. Казалось бы, нет ничего лучше вегетативного размножения. Но у него есть один большой недостаток. С каждым поколением растение накапливает в себе различные болезни, и желательно не продолжать род дольше 4-х поколений. Тут приходит на помощь микроклональное размножение, которое, по сути, тоже вегетативное, но за счет некоторых техник позволяет получить материал, свободный от вирусов, бактерий и грибков.
Уже поел своего васаби?
Год прошел со дня высадки васаби на гидропонику. До нормального увеличения корневищ я подождал бы ещё месяцев 8. Вот так выглядел два месяца назад куст, который получился из японской версии материала.

До зрелости конкретно этим ребятам вырасти не получится, т.к. я их благополучно пускаю на микроклональные опыты. Зато у меня полно васабьих листьев, которые с удовольствием готовлю разными способами и это очень вкусно, они тоже обладают остротой, хотя и не такой сильной как корневище. Особенно хороши они в маринованном виде.
От некоторых экспериментов у меня оставались маленькие кусочки корневища, которые я, конечно же, пробовал. Даже купил специальную терку из акульей кожи.

Мне неоднократно задавали вопрос, на что похож вкус васаби. В целом, вкус васаби уникален и поэтому похож на вкус васаби, но не того, что из порошка. Первое, что ощущается при поедании настоящего васаби — легкая сладость, за которой следует эффект от горчичных масел: острота и характерный «удар в нос», ну и в совокупности с собственным запахом это дает уникальную картинку. У порошкового васаби такого запаха нет.
Конец первой части
Мне удалось заполучить живые растения васаби и даже немного размножить. Следующий этап на пути к моей мечте — научиться размножать васаби микроклональным способом и получить здоровый посадочный материал для создания своей фермы. Во второй части я расскажу вам о превращении бытовки в лабораторию для микроклонального размножения растений и про свои успехи с васаби.
На момент написания поста эксперименты по введению васаби в культуру in-vitro ещё продолжаются и нужного результата я пока не добился, но уверен, что всё получится. Следите за процессом в моем телеграм-канале. Там я публикую отчеты о проведенных экспериментах, а так же рассказываю о других личных проектах, связанных с растениями.
До связи!
Автор: Александр Дмитриев
